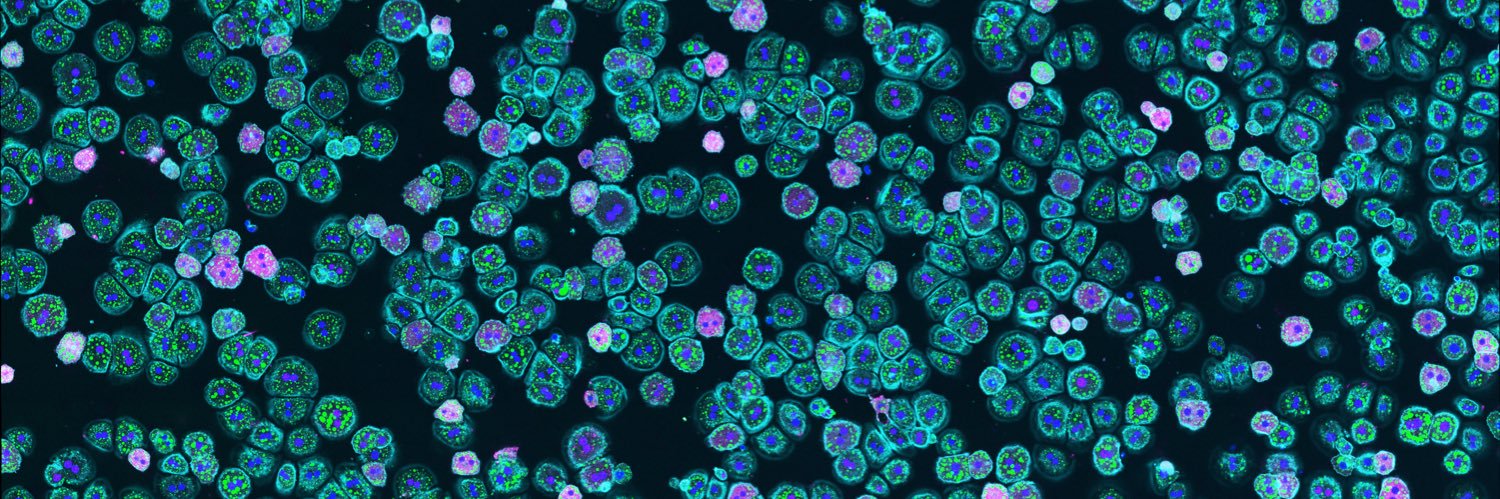
Macleod Lab - University of Chicago banner

Macleod Lab - University of Chicago
846 posts

Macleod Lab - University of Chicago
@LabMacleod
Understanding Cancer to Cure Cancer! (Opinions are my own)











Congratulations to my colleague & friend from the Department of Biochemistry & Molecular Genetics, Dr. Issam Ben-Sahra, @bensahralab on being honored with the Thomas D. Spies Professor of Genetic Metabolism endowed professorship at @NUFeinbergMed. This is a well-deserved recognition of your outstanding contributions & leadership in the field of metabolism. I am truly proud of you and the entire Ben-Sahra Lab. Wishing you continued success — the best is yet to be! @NU_BMG_SQE @theNASciences @CellReports @ScienceMagazine @Nature





Backed by a $100M gift from Joan and Sandy Weill, UCSF and @StanfordMed @StanfordCancer are launching Weill Cancer Hub West, a $200M initiative in team science to accelerate cancer research and improve care over the next decade. tiny.ucsf.edu/ppVRqt




















